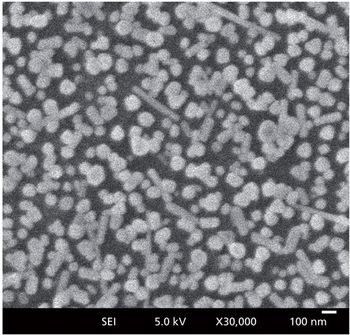
Wu-figure1_web.jpg

Heinz W. Siesler, Emeritus Professor at University of Duisburg-Essen, reviews Jerry Workman’s new book, The Concise Handbook of Analytical Spectroscopy Theory, Applications, and Reference Materials


Heinz W. Siesler, Emeritus Professor at University of Duisburg-Essen, reviews Jerry Workman’s new book, The Concise Handbook of Analytical Spectroscopy Theory, Applications, and Reference Materials

Raman spectroscopy can be used to determine the temperature of a material when other more direct means are either impractical or not possible. The material’s temperature can affect the peak position of Raman bands. When a Raman band shifts significantly with temperature, the monitoring of the peak position can be the most straightforward manner of determining temperature provided the Raman spectrometer has sufficient spectral resolution. Another method is to determine the temperature from the ratio of the Stokes and anti-Stokes signal strengths of a given Raman band. The latter method requires the ability to detect light at wavelengths longer and shorter than that of the laser and an accurate measurement of the wavelength dependent instrument response function.

When characterizing microscale objects using a Raman microscope, certain basic practical aspects of analytical instrument performance and experimental design should be taken into consideration.

The accurate determination of protein structure is integral to the medical and pharmaceutical communities’ ability to understand disease, and develop drugs. Current techniques (CD, IR, Raman) for protein structure prediction provide results that can be poorly resolved, while high resolution techniques (NMR, X-ray crystallography) can be both costly and time-consuming. This work proposes the use of drop coat deposition confocal Raman spectroscopy (DCDCR), coupled with peak fitting of the Amide I spectral region (1620–1720 cm-1) for the accurate determination of protein secondary structure. Studies conducted on BSA and ovalbumin show that the predictions of secondary structure content within 1% of representative crystal structure data is possible for model proteins. The results clearly demonstrate that DCDCR has the potential to be effectively used to obtain accurate secondary structure distributions for proteins.

Spectroscopy is proud to have created a new award, the Emerging Leader in Molecular Spectroscopy Award. As its name implies, the award recognizes a young scientist, and it is designed to encourage the next generation of molecular spectroscopists. Matthew Baker, the winner of the inaugural Emerging Leader in Molecular Spectroscopy Award, is a senior lecturer in chemistry at the University of Strathclyde, in Glasgow, Scotland. At Strathclyde, Baker leads research to advance the application of analytical chemistry to real-world problems in a variety of areas, including the biomedical, clinical, defense, and security fields. His main focus is the development of spectroscopic and spectrometric molecular pathology, disease diagnosis, and the detection of pathogenic bacteria and toxic chemicals. In particular, Baker has pioneered the use of vibrational spectroscopy for clinical diagnostics.

Photoluminescence can provide information about the composition and solid state structure of a material. The high spectral resolution of a Raman spectrometer can be useful in performing photoluminescence spectroscopy of solid state materials, particularly when the emission spectra consist of narrow bands or even lines. Having the capability to perform photoluminescence and Raman spectroscopies simultaneously with the same instrument is advantageous, especially when studying 2D crystals. When used to perform photoluminescence spectroscopy, the Raman spectrometer becomes two instruments in one.

The development of novel, nondestructive technologies for rapid analysis of evidence discovered at crime scenes is pertinent to our criminal justice system to solve the millions of violent crimes that occur each year. Without a witness, establishing the precise timeline of a crime is difficult. Therefore, technologies based on sensitive, nondestructive techniques are needed to evaluate evidence and create such a timeline. We propose the use of Raman spectroscopy to analyze the age of bloodstains for potential use as a forensics tool. Previous studies have revealed Raman spectroscopy is sensitive to changes in blood analyte concentration and different oxidative states of hemoglobin. Raman spectroscopy could allow for rapid comparison of spectra from blood stains of unknown age to spectra of known age with high temporal accuracy. Though further investigation into other substrates and biochemical components should be performed, our study reveals Raman spectroscopy has the potential to accurately and nondestructively determine the age of a bloodstain for use in criminal investigations.

Raman spectroscopy is a well-suited spectroscopic technique for process development and control within development labs in chemical, pharmaceutical, and other industries. This article demonstrates the utility of portable Raman spectroscopy as a simple and versatile tool for in-situ monitoring of reactions using univariate analysis such as peak trending, as well as multivariate analysis approaches to predict the end point of chemical reactions. Using portable Raman systems allows users to make measurements in the lab, but also serves as a proof of concept for the Raman measurements to be implemented at-line or on-line in small pilot plants or large scale production sites. For known reactions that are repetitively performed, or for continuous online process monitoring of reactions, the present approach provides a convenient solution for process understanding and the basis for future implementation.

The availability of quality drugs is crucial in the event of a pandemic. Here, we report our pilot efforts to perform rapid screening of anti-infective drugs for confirmation of drug product quality using near infrared and Raman library methods. The methods reported are nondestructive towards the sample and are designed to facilitate rapid physical testing of drugs at the point of use or in a field setting. We built a representative library through voluntary collaboration with six different manufacturers of antibiotic and antiviral drugs. The drugs supplied by these manufacturers are representative of imported U.S. FDA approved finished products. We successfully transferred the spectral libraries from laboratory-based instruments to field-deployable handheld near infrared and Raman instruments and challenged the library methods using independent samples from different batches.

In this paper, we examine the relative performance of 532 and 785 nm portable Raman systems, as well as demonstrate an automated analytical methodology applicable for carbon nanotube (CNT) characterization and quality control applications. Both 532 and 785 nm Raman spectra were used to directly analyze and compare important CNT structural parameters and properties including CNT diameters, diameter distributions, CNT structural quality (% of defects), CNT types, and other properties. The data indicate advantages in a number of areas for using 532 versus 785 nm excitation for CNT Raman measurements.

This article verified the Brill transition in nylon 6,6 by Raman spectroscopy through heating and cooling processes of the sample. When nylon is heated at around 160 C a crystalline phase transition occurs from a triclinic structure at room temperature to a pseudohexagonal structure above that temperature. This phase transition is known as the Brill Transition. With temperature-dependent Raman scattering measurements, it was possible to determine the vibrational behavior of nylon 6,6 during the Brill transition, and consequently to identify the main Raman bands associated with the Brill transition.

Raman spectroscopy is particularly useful for identification of contaminant materials in pharmaceuticals because it can very clearly and nondestructively identify materials. Raman spectroscopy can be used to identify foreign matter on tablets as well as the individual tablet materials to confirm the material’s legitimacy. For injectable drug vials, Raman spectroscopy can be used with microscopy to count, size, and identify particulate contamination found in such vials. Spectral interpretation is key to the value of Raman spectroscopy, and it is important for accuracy of identification not to simply rely on library match values.

Cosmetic preparations are common consumer products that consist of various organic and inorganic materials. In this paper, a method for the identification and spatial discrimination of the components in eye shadow samples using laser Raman microspectroscopy is described. The use of a multivariate curve resolution (MCR) is utilized during the analysis of the cosmetic preparation mapping data to develop the spatial discrimination information presented within this note.

Analytical quality control (AQC) is an established application of Raman spectroscopy in many industrial fields. The extension of Raman spectroscopy as an AQC method in hospital environments imparts the benefits of a noninvasive and nondestructive analysis. The literature in using Raman spectroscopy as an AQC method for chemotherapy preparation and anesthesia gas monitoring is reviewed. Future applications in tissue engineering and incorporating new Raman techniques into AQC are also discussed.

Recent advances in Raman instrumentation have resulted in the development of easy-to-use and efficient handheld Raman analyzers. Most of the commercially available handheld Raman devices utilize 785 or 1064 nm excitation. This paper directly demonstrates the performance of 532 nm handheld Raman (versus 785 and 1064 nm) for the analysis of biopharmaceuticals for structure and counterfeit testing as well as explosive detection (TSA screening and CSI applications). The results presented here will contribute to recognition of 532 nm Raman excitation as a highly attractive option for a rapid “in-place” analysis in the field.

Aligned semiconducting single-walled carbon nanotubes (s-SWCNTs) are expected to outperform silicon as the next generation of integrated circuits. Greater utilization of polarized Raman spectroscopy is proving beneficial for efficient characterization of alignment in CNT films. Here, we present the results of how polarized Raman imaging can be used to effectively characterize alignment in large regions of aligned s-SWCNT films.

Colin Campbell discusses his work applying SERS to biomedical applications.

Our annual review of products introduced at Pittcon or during the previous year, broken down by the following categories: accessories, atomic spectroscopy, components, imaging, mass spectrometry, mid-IR, NIR, NMR, Raman, software, UV-vis, and X-ray.

In recent years, Raman spectroscopy has been applied to process monitoring and control applications in a wide range of application fields, including bioprocessing, pharmaceuticals, food, oil and gas, and oceanography. Brian Marquardt, cofounder and CEO of MarqMetrix, Inc., and director and senior principal engineer with the Center for Process Analysis and Control in the Applied Physics Laboratory at the University of Washington, has more than 15 years of experience with such applications and recently spoke with us about his research.

Matthew Baker, a senior lecturer in chemistry at the University of Strathclyde, in Glasgow, has won the inaugural Emerging Leader in Molecular Spectroscopy Award, which is sponsored by Spectroscopy magazine. This new annual award recognizes the achievements and aspirations of a talented young molecular spectroscopist, selected by an independent scientific committee. The award will be presented to Baker at the SciX 2016 conference in September, where he will give a plenary lecture and be honored in an award symposium.

Were it not for the problem of photoluminescence, only one laser excitation wavelength would be necessary to perform Raman spectroscopy. Here, we examine the problem of photoluminescence from the material being analyzed and the substrate on which it is supported. Selecting an excitation wavelength that does not generate photoluminescence reduces the noise level and yields a Raman spectrum with a superior signal-to-noise ratio. Furthermore, we discuss the phenomenon of resonance Raman spectroscopy and the effect that laser excitation wavelength has on the Raman spectrum.

The use of Raman spectroscopy to produce material images whose contrast is derived from chemical or crystallographic species has been seen as quite useful since the introduction of the Raman microscope in 1976, but particularly, more recently, with the development of more sensitive and easier-to-use instruments. When the various species in the field of view have spectra with non-overlapping analytical bands, simple univariate analysis can provide good images. When overlapping bands are present, multivariate techniques, especially MCR (Multivariate Curve Resolution), have been successfully applied. However, there are cases where even MCR results may be problematic. We will look at some maps of a ceramic composite containing SiC, Si, B4C, and Carbon, where each of these species has non-unique spectra to see what type of results flexible software can produce. What is the goal in this type of exercise? For some of us, creating images is like a teenager’s computer game. But really what we are trying to do is to extract information about a sample from its Raman image. A beautiful rendition is nice, but it must yield information. The following will show how Raman maps can provide useful information on a sample.

Crystallinity is an important factor when producing pharmaceuticals as it directly affects the bioavailability of the drug. Low frequency Raman spectroscopy offers some advantages to the detection and analysis of crystallinity in pharmaceutical samples. Here the experimental requirements for low frequency Raman measurements are described. The application to the study of crystallinity with a number of examples is discussed and the advantages and limitations of this technique are highlighted and compared with other techniques.
In this paper, we demonstrate a sensitive surface-enhanced Raman spectroscopy (SERS) substrate for trace dimethoate detection. The substrate is composed of Ag nanoparticle/probe/smooth Au film stack configuration. The nanogap formed by an Ag nanoparticle and a macroscopically flat Au film is one kind of “hot site” which will dramatically increase the total “hot spots” number.

Imaging techniques using vibrational spectroscopy, mass spectrometry (MS), and atomic force microscopy have all been advancing and gaining momentum in recent years. There is great potential power in these imaging techniques, particularly in the biomedical field. Thomas Bocklitz of at the Friedrich-Schiller-University Jena is working to better harness the power of these techniques by combining them.